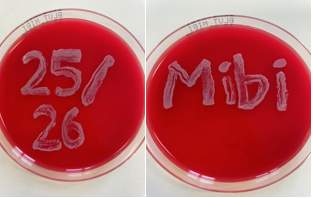

Herzlich Willkommen !
Am 24.10.2025 beginnen die Vorlesungen und das Praktikum ( 07.11.2025) für die Med. Mikrobiologie, Virologie und Hygiene.
Hierzu ein paar Informationen:
Der Eingang zu den Praktikumsräumen befindet sich links neben dem Hörsaal C Zentrales Forschungsgebäude, Liebigstraße 21.
Sie benötigen für das Praktikum:
- weißer Kittel, 1€ für den Spind und geschlossenes Schuhwerk
- das Praktikumsskript in ausgedruckter Version ( elektronische Geräte sind in den Praktikumsräumen nicht gestattet)
Krankmeldungen erfolgen bitte über das Sekretariat der Med. Mikrobiologie Tel.: 15200 oder per Mail an Claudia.Skibitzki@med.uni-leipzig.de und L.Mueller@medizin.uni-leipzig.de
Termine:
- Prüfung : 06.02.2026, 13:00-13:45, Hörsaal C Zentrales Forschungsgebäude, Liebigstraße 21
- WH-Prüfung: 20.02.2026. 13:00-13:45, Hörsaal C Zentrales Forschungsgebäude, Liebigstraße 21
- Trainer/in: Nadine Dietze
- Trainer/in: Ines Eder
- Trainer/in: Annett Hennig-Rolle
- Trainer/in: Christian Jassoy
- Trainer/in: Norman Lippmann
- Trainer/in: Lisa Müller
- Trainer/in: Jasmine Neumann
- Trainer/in: Maike Rebenstorff
- Trainer/in: Claudia Skibitzki
- Trainer/in: Catalina Suzana Stingu
- Trainer/in: Dinah von Schöning
Semester: WiSe 2025/26
- Trainer/in: Christian Jassoy
Semester: WiSe 2022/23